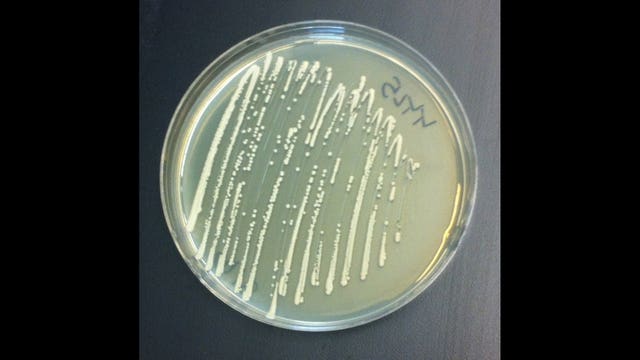
Inslee takes executive action to fight opioid addiction

Infant died of starvation after parents' overdose deaths, Pennsylvania coroner says
JOHNSTOWN, Pa. (AP) — A coroner says a 5-month-old Pennsylvania girl starved to death in her bassinet after her parents died of drug overdoses.The Cambria County coroner's office said autopsy and toxicology reports confirmed that Summer Chambers died of dehydration and starvation in the home in Kernville, about 60 miles east of Pittsburgh, a few days before Christmas.Coroner Jeff Lees called the case "heart-wrenching" and ruled the infant's death homicide due to parental neglect.Lees says toxicology tests indicate that 27-year-old Jaron Chambers and 19-year-old Chelsea Cordaro died of acute fentanyl overdoses.
JOHNSTOWN, Pa. (AP) — A coroner says a 5-month-old Pennsylvania girl starved to death in her bassinet after her parents died of drug overdoses.The Cambria County coroner's office said autopsy and toxicology reports confirmed that Summer Chambers died of dehydration and starvation in the home in Kernville, about 60 miles east of Pittsburgh, a few days before Christmas.Coroner Jeff Lees called the case "heart-wrenching" and ruled the infant's death homicide due to parental neglect.Lees says toxicology tests indicate that 27-year-old Jaron Chambers and 19-year-old Chelsea Cordaro died of acute fentanyl overdoses.
Seattle, King County moving ahead with first-in-nation 'safe injection sites' for drug addicts
Seattle Mayor Ed Murray and King County Executive Dow Constantine say they're going ahead with plans to create safe injection sites where people can use heroin or other opioids under the watch of medical professionals.
Seattle Mayor Ed Murray and King County Executive Dow Constantine say they're going ahead with plans to create safe injection sites where people can use heroin or other opioids under the watch of medical professionals.
State Sen. Miloscia introduces bill to block supervised heroin and opioid injection sites in King County
SEATTLE -- It’s not only a national epidemic, it’s a local one as well.
SEATTLE -- It’s not only a national epidemic, it’s a local one as well.
On death’s door: The fight to save a heroin addict’s life
An hour before the frantic scene began to unfold, Seattle Police Officers Randy Jokela and Jason Drummond were on their regular beat. Combined, the two have patrolled downtown Seattle for nearly a half-century.
An hour before the frantic scene began to unfold, Seattle Police Officers Randy Jokela and Jason Drummond were on their regular beat. Combined, the two have patrolled downtown Seattle for nearly a half-century.
Heroin Hits Home: the deadly comeback of an old drug
Q13 News' Brandi Kruse joined police on the front lines of the battle against the deadly drug where they were faced with the deadly reality of heroin, an old drug that is claiming new victims every single day.
Q13 News' Brandi Kruse joined police on the front lines of the battle against the deadly drug where they were faced with the deadly reality of heroin, an old drug that is claiming new victims every single day.
Seattle police warn people about dangerous heroin purity
SEATTLE -- Seattle police are warning heroin users about dangerous purity levels after several recent overdoses.Police spokesman Sgt.
SEATTLE -- Seattle police are warning heroin users about dangerous purity levels after several recent overdoses.Police spokesman Sgt.
Police respond to 4 overdoses along the Aurora corridor Saturday
In less than 24 hours, Seattle police and fire officials responded to four overdoses along the Aurora corridor in North Seattle Saturday. Three of those incidents were fatal. The fourth patient is receiving emergency care at Harborview Medical Center.
In less than 24 hours, Seattle police and fire officials responded to four overdoses along the Aurora corridor in North Seattle Saturday. Three of those incidents were fatal. The fourth patient is receiving emergency care at Harborview Medical Center.
Mother's powerful words after daughter dies in Taco Bell of apparent overdose
ASHEBORO, N.C. -- Nobody ever wins against the devil, not without help.Those are the words of a North Carolina mother who is speaking out about heroin addiction after her daughter was found dead of an apparent overdose in a Taco Bell restaurant Thursday.Twenty-two years ago, Claudia Marini said she chose strong names for her daughter, Madison Bailey Marini.
ASHEBORO, N.C. -- Nobody ever wins against the devil, not without help.Those are the words of a North Carolina mother who is speaking out about heroin addiction after her daughter was found dead of an apparent overdose in a Taco Bell restaurant Thursday.Twenty-two years ago, Claudia Marini said she chose strong names for her daughter, Madison Bailey Marini.
Seattle police used lifesaving overdose reversal drug 15 times in 2016
For the 15th time in 2016, Seattle police used Naloxone to save a person suffering from a drug overdose.
For the 15th time in 2016, Seattle police used Naloxone to save a person suffering from a drug overdose.
Police asking for help finding woman convicted of heroin possession
The Olympic Peninsula Narcotics Enforcement Team is asking for the public's help in finding a woman convicted of heroin possession.Port Angeles’ Stephanie Dawn Lingvall, 32, has not appeared to serve her time in jail.Lingvall was arrested Jan. 31, 2016 after detectives with the Olympic Peninsula Narcotics Enforcement Team (OPNET) were able to purchase heroin from her.Lingvall was granted a court ordered release, but failed to show up to court as instructed.A $2,500 warrant was issued and she was arrested on July 1.At the time of her arrest, officers with the Port Angeles Police Department developed probable cause that she was in possession of heroin at the time.
The Olympic Peninsula Narcotics Enforcement Team is asking for the public's help in finding a woman convicted of heroin possession.Port Angeles’ Stephanie Dawn Lingvall, 32, has not appeared to serve her time in jail.Lingvall was arrested Jan. 31, 2016 after detectives with the Olympic Peninsula Narcotics Enforcement Team (OPNET) were able to purchase heroin from her.Lingvall was granted a court ordered release, but failed to show up to court as instructed.A $2,500 warrant was issued and she was arrested on July 1.At the time of her arrest, officers with the Port Angeles Police Department developed probable cause that she was in possession of heroin at the time.
Man, woman accused of trafficking heroin, keeping explosives
BELLINGHAM, Wash. (AP) _ Whatcom County authorities say they have arrested a man and woman on suspicion of selling heroin and having guns and explosives in their home.The Bellingham Herald reports (http://bit.ly/2fpz6P6 ) that the two suspects were taken into custody without incident Wednesday at their Everson home.The sheriff's office says the arrests followed a months long investigation involving undercover officers who purchased heroin from the two suspects at the residence.Deputies say they seized three guns from the home, heroin and two pipe bombs, which were found to contain explosive material.The 27-year-old male suspect appeared in court Thursday and was ordered held on $100,000 bail.
BELLINGHAM, Wash. (AP) _ Whatcom County authorities say they have arrested a man and woman on suspicion of selling heroin and having guns and explosives in their home.The Bellingham Herald reports (http://bit.ly/2fpz6P6 ) that the two suspects were taken into custody without incident Wednesday at their Everson home.The sheriff's office says the arrests followed a months long investigation involving undercover officers who purchased heroin from the two suspects at the residence.Deputies say they seized three guns from the home, heroin and two pipe bombs, which were found to contain explosive material.The 27-year-old male suspect appeared in court Thursday and was ordered held on $100,000 bail.
Spanaway mom charged for allegedly injecting her kids with heroin -- 'feel good medicine'
SPANAWAY -- A 24-year-old Spanaway mother of three has been charged with injecting her children with heroin.
SPANAWAY -- A 24-year-old Spanaway mother of three has been charged with injecting her children with heroin.
Heartbreaking video shows dad telling 8-year-old son mom died of heroin overdose
YOUNGSTOWN, Ohio -- Video of an Ohio father telling his 8-year-old son that his mother died of an overdose is going viral -- and is also attracting some criticism.Facebook user Brenden Bickerstaff-Clark, who lists himself as being from Youngstown, posted the video Monday.FOX 8 blurred his child's face to protect the boy's identity.
YOUNGSTOWN, Ohio -- Video of an Ohio father telling his 8-year-old son that his mother died of an overdose is going viral -- and is also attracting some criticism.Facebook user Brenden Bickerstaff-Clark, who lists himself as being from Youngstown, posted the video Monday.FOX 8 blurred his child's face to protect the boy's identity.
Inslee takes executive action to fight opioid addiction
SEATTLE -- Gov.
SEATTLE -- Gov.
Cops: Child in diapers locked in closet for 12 hours while mom allegedly took heroin and shoplifted
PHOENIX -- A Phoenix mother has been arrested for child abuse after her three-year-old daughter was found locked in a closet.
PHOENIX -- A Phoenix mother has been arrested for child abuse after her three-year-old daughter was found locked in a closet.
Heroin horror: Facebook video captures unconscious couple on sidewalk
MEMPHIS, Tenn. — A live Facebook video showing two people unconscious on a Memphis sidewalk is going viral.According to police, the two people said they "snorted some heroin" in a nearby Walgreens bathroom.Someone driving by saw them on the sidewalk at South Pauline Street and Eastmoreland Avenue around 3:30 p.m. Monday and called 911, according to WREG.
MEMPHIS, Tenn. — A live Facebook video showing two people unconscious on a Memphis sidewalk is going viral.According to police, the two people said they "snorted some heroin" in a nearby Walgreens bathroom.Someone driving by saw them on the sidewalk at South Pauline Street and Eastmoreland Avenue around 3:30 p.m. Monday and called 911, according to WREG.
Friend charged in Marysville heroin overdose death
EVERETT, Wash. -- A 30-year-old woman has been charged with the death of a man who overdosed on heroin inside a parked vehicle in Marysville.The Daily Herald reports Gabrielle Waller has pleaded not guilty to controlled substance homicide in 35-year-old Ian Digre's March death.Court documents say Digre had asked Waller to buy $20 worth of heroin and that the two friends met up for the drug deal.Police suspect Waller was in the vehicle with Digre when he injected the heroin and that she took the $20 before leaving him there to die without calling for help.Charging papers say Waller fled because she was concerned about getting arrested on an outstanding warrant.Digre was found dead the following day by children who noticed him in the vehicle and called police.
EVERETT, Wash. -- A 30-year-old woman has been charged with the death of a man who overdosed on heroin inside a parked vehicle in Marysville.The Daily Herald reports Gabrielle Waller has pleaded not guilty to controlled substance homicide in 35-year-old Ian Digre's March death.Court documents say Digre had asked Waller to buy $20 worth of heroin and that the two friends met up for the drug deal.Police suspect Waller was in the vehicle with Digre when he injected the heroin and that she took the $20 before leaving him there to die without calling for help.Charging papers say Waller fled because she was concerned about getting arrested on an outstanding warrant.Digre was found dead the following day by children who noticed him in the vehicle and called police.
Heartbreaking video shows toddler trying to wake mother after overdose
Video shot in a Dollar Store Sunday morning shows just how heartbreaking drug addiction can be.
Video shot in a Dollar Store Sunday morning shows just how heartbreaking drug addiction can be.
Dog eats heroin tossed away by suspected dealer running from police
DENVER, Colo. -- A golden retriever is one of the latest victims of the heroin trade in Denver.On Tuesday, officers saw a suspected drug dealer at West 14th Avenue and Speer Boulevard, near the Cherry Creek bike path.According to the Denver Police Department, the suspect ran and was caught near West 13th Avenue and Kalamath Street.
DENVER, Colo. -- A golden retriever is one of the latest victims of the heroin trade in Denver.On Tuesday, officers saw a suspected drug dealer at West 14th Avenue and Speer Boulevard, near the Cherry Creek bike path.According to the Denver Police Department, the suspect ran and was caught near West 13th Avenue and Kalamath Street.
Snohomish Co. holds forum to try to find ways to end heroin epidemic
LAKE STEVENS, Wash. -- We know people are addicted and we know people are dying.
LAKE STEVENS, Wash. -- We know people are addicted and we know people are dying.